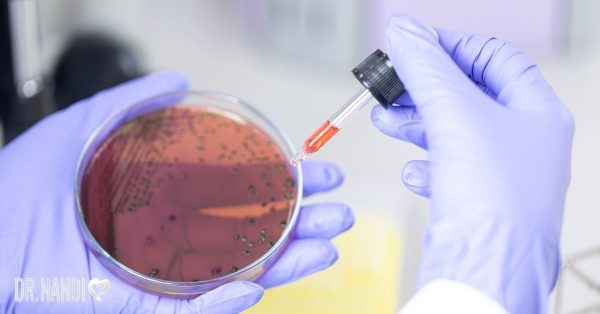
Living With Rheumatoid Arthritis From Diagnosis To Treatment Living With Rheumatoid Arthritis From Diagnosis To Treatment

Escalating Malaria Cases And Prevalence Of Rheumatoid
What are common symptoms and treatments for rheumatoid arthritis?.
Rheumatoid arthritis is a chronic inflammatory autoimmune disease of unknown origin with a variable progression. it primarily impacts the joints but can also affect the internal organs. about 1. 3 million adults in the united states are affe. Hydroxychloroquine is used to treat: rheumatoid arthritis discoid and systemic lupus erythematosus (sle) juvenile idiopathic arthritis (jia).
Arthritis is something that affects roughly 40 million u. s. citizens, both young and old. this disease comes in over 100 different forms and is treated in various ways, one of which is through injections. the inflammation and stiffness that. More hydroxychloroquine in rheumatoid arthritis images. Common side effects associated with hydroxychloroquine include 5: headache dizziness loss of appetite nausea diarrhea stomach pain vomiting skin rash hypoglycemia (low blood sugar). May 20, 2021 · 1. among a large, matched cohort of veterans with rheumatoid arthritis, initiation of hydroxychloroquine was not associated with a higher risk of adverse cardiovascular events or death. evidence rating level: 1 (excellent) in anecdotal case reports, hydroxychloroquine (hcq) has been reported to prolong the qt interval, thus increasing the risk of arrhythmia and sudden cardiac
Hydroxychloroquine Sideeffects Uses Time To Work
According to the american college of rheumatology, hydroxychloroquine (plaquenil), is a “disease-modifying anti-rheumatic drug (dmard),” meaning that it helps reduce the pain and swelling that come with arthritis. it can also reduce the incidence of joint damage, thus lessening the risk of developing a long-term disability from complications of ra. Find rheumatoid arthritis news articles, videos, blogs, books, continuing medical education (cme), meeting coverage, and journal hydroxychloroquine in rheumatoid arthritis articles. get the latest news and education delivered to your inbox ©2021 healio all rights reserved. get the l.
Arthritis Treatment Through Injections
Hydroxychloroquine is a treatment for malaria but has been shown to have an effect on the messaging system between cells by interrupting the inflammatory response. it is this mechanism that is beneficial in both ra and juvenile idiopathic arthritis (jia). A variety of placebo-controlled and open studies have demonstrated the effectiveness of hydroxychloroquine in the treatment of rheumatoid arthritis. the excellent responses to recurrent treatment in a sample patient illustrate the value of hydroxychloroquine. because low daily doses of hydroxychloroquine are associated with greater ophthalmologic safety, it would be advantageous to use the smallest effective daily dose, but there are no published controlled efficacy studies using daily doses.
The mechanisms of hydroxychloroquine in rheumatoid arthritis treatment: inhibition of dendritic cell functions via toll like receptor 9 signaling 1. introduction dendritic cells (dcs) are powerful antigen-presenting cells and play a vital function in inducing and 2. materials and methods 2. 1. The anti-malarial drug lowers cholesterol and blood sugar and makes blood less sticky, which is good for reducing blood clots and heart attack risk. if you take the anti-malarial drug hydroxychloroquine (plaquenil) as part of your treatment for lupus or rheumatoid arthritis (ra), you may be getting cardiovascular protection as an added bonus. Affecting more than 1. 3 million americans (and as much as 1% of the hydroxychloroquine in rheumatoid arthritis world’s population), rheumatoid arthritis (ra) is one of the more common autoimmune disorders and chronic illnesses in the united states. this health condition involves lon.
Hydroxychloroquine (plaquenil) is an older dmard sometimes still used for mild hydroxychloroquine in rheumatoid arthritis ra. plaquenil is used with other medications to treat auto-immune diseases like rheumatoid arthritis and lupus. this treatment option is recommended with medications that work to improve the condition or a certain medication can’t be given to a patient. See more videos for hydroxychloroquine in rheumatoid arthritis.
Rheumatoid arthritis wikipedia.
Treatment of rheumatoid arthritis: american college of rheumatology guidelines 2021 by dr satabdi saha published on 2021-06-16t15:00:02+05:30 updated on 2021-06-16t09:40:12+05:30 the american college of rheumatology has updated guidelines for the pharmacologic management of rheumatoid arthritis. Hydroxychloroquine has hydroxychloroquine in rheumatoid arthritis an average rating of 6. 4 out of 10 from a total of 114 ratings for the treatment of rheumatoid arthritis. 46% of those users who reviewed hydroxychloroquine reported a positive effect, while 25% reported a negative effect. Jun 16, 2021 · hydroxychloroquine drugs are types of oral medications. these medications are used for treating autoimmune diseases such as rheumatoid arthritis and others. No one enjoys being in pain as they age. unfortunately, 12 percent of the population has osteoarthritis. that's nearly 21 million americans, and the percentage of people who have it increases with age. rheumatoid arthritis (ra) affects anot.
Rheumatoid arthritis is best diagnosed by a rheumatologist, a type of doctor that is a specialist in arthritis and autoimmune diseases. to diagnose rheumatoid arthritis, a doctor will take a complete history and perform a thorough physical examination. they will usually order blood tests and x-rays to help confirm their diagnosis. Rheumatoid arthritis (ra) is a type of autoimmune arthritis where your body’s immune system attacks its own tissue, including joints and internal organs, causing pain and swelling. learn more. Jul 29, 2020 · hydroxychloroquine is an oral drug. it was originally used to prevent and treat malaria. today, it’s approved by the food and drug administration (fda) to treat ra. Arthritis is a general term for a group of painful conditions that involve inflammation and stiffness of the joints. the different types of arthritis can occur in any joint in the body, including the hands, shoulders, knees, hips and ankles.
Jan 10, 2012 · hydroxychloroquine best prices! ©a greater incidence of retinopathy has actually been reported when the upkeep dosage for rheumatoid arthritis as well as lupus. The pain and stiff joints caused by arthritis can make it difficult to enjoy everyday activities. taking an over-the-counter pain reliever like aleve can get you back to feeling like yourself without letting arthritis keep you on the sideli. Hydroxychloroquine is not effective against all strains of malaria, or against malaria in areas where the infection has been resistant to a similar drug called chloroquine. hydroxychloroquine is also used to treat symptoms of rheumatoid arthritis and discoid or systemic lupus erythematosus.

Originally, hydroxychloroquine was used to prevent and treat malaria and was considered very effective. now it is generally used for rheumatoid arthritis, but it has also been shown to work well for juvenile arthritis, some lupus symptoms, and other types of autoimmune conditions. Rheumatoid arthritis (ra) is a hydroxychloroquine in rheumatoid arthritis long-term autoimmune disorder that primarily affects joints. it typically results in warm, swollen, and painful joints. pain and stiffness often worsen following rest. most commonly, the wrist and hands are involved, with the same joints typically involved on both sides of the body. As an autoimmune disease, rheumatoid arthritis is both painful and difficult to diagnose, especially during the early stages. part of the problem is that various other diseases, such as lupus and fibromyalgia, can be mistaken for rheumatoid. Rheumatoid arthritis is a chronic disorder for which there is no known cure. fortunately in the last few years, a shift in strategy toward the earlier institution of disease modifying drugs and the availability of new classes of medications have greatly improved the outcomes that can be expected by most patients.
0 komentar:
Posting Komentar